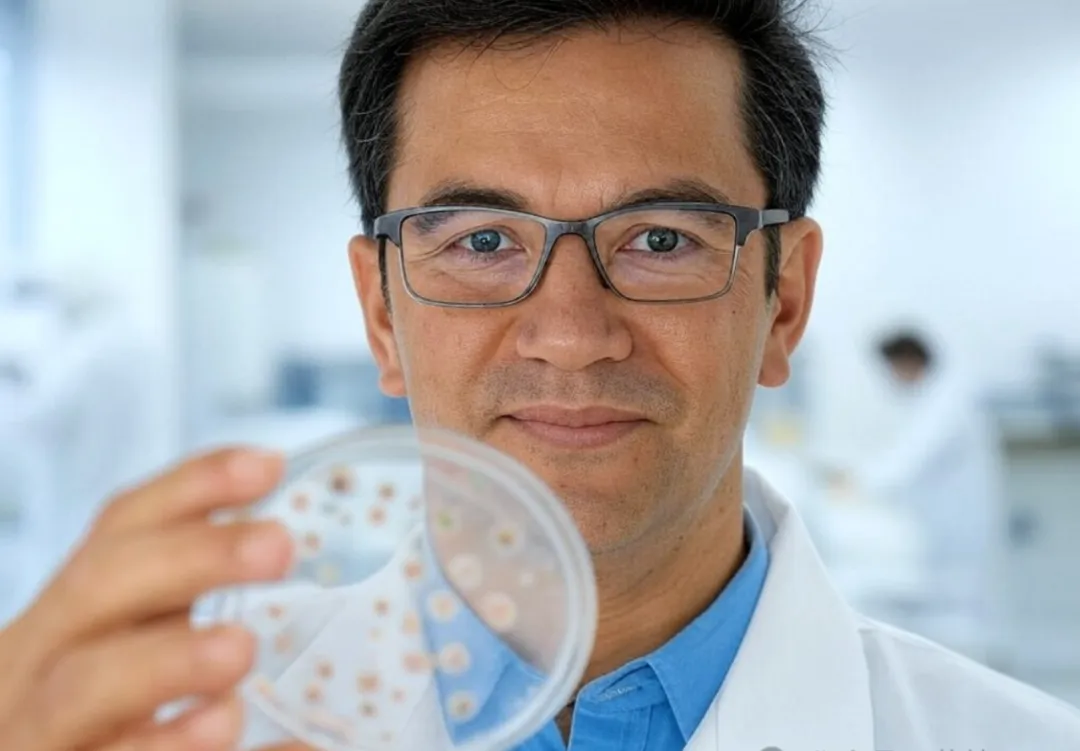
1740400700003.jpg 1740400700003.jpg

全球矚目!干細(xì)胞療法(IPS HEART)獲FDA孤兒藥資格,罕見病患者重見曙光!
引言
GIVI-MPC干細(xì)胞療法孤兒藥資格(ODD)獲批標(biāo)志著干細(xì)胞療法在攻克罕見遺傳性肌肉疾病領(lǐng)域取得了重要里程碑,為數(shù)百萬患者帶來了新的希望。

2025年1月13日,美國食品藥品監(jiān)督管理局(FDA)宣布授予 IPS HEART 的 GIVI-MPC 干細(xì)胞療法孤兒藥資格(ODD),用于治療貝克爾型肌營養(yǎng)不良癥(BMD)。
BMD是一種由于基因缺陷導(dǎo)致的肌肉退化性疾病,患者的肌肉中抗病蛋白——抗肌萎縮蛋白部分缺失或變異,導(dǎo)致肌肉逐漸衰退。
而IPS HEART的GIVI-MPC干細(xì)胞療法,其獨(dú)特之處在于能夠生成帶有100%全長度人類抗肌萎縮蛋白的新肌肉組織,這在現(xiàn)有的基因療法中尚屬首次。

干細(xì)胞療法的顛覆性潛力
與傳統(tǒng)的基因療法相比,GIVI-MPC不僅提供了全長度的抗肌萎縮蛋白,更能夠直接重建新的肌肉組織,從而從根本上改變疾病的進(jìn)程。
不僅如此,IPS HEART的研發(fā)并未止步于骨骼肌療法。其ISX-9-CPC療法在治療杜氏肌營養(yǎng)不良癥心肌病方面也取得了顯著進(jìn)展,已榮獲罕見兒科藥物資格,并通過了FDA的臨床試驗(yàn)初步方案審批。這款基于多能干細(xì)胞技術(shù)(iPSC)的心臟療法,能夠生成新的功能性心肌組織,為心肌損傷的治療開辟了新的途徑。
BMD和DMD這兩種遺傳性疾病長期以來被視為無法逆轉(zhuǎn)的絕癥,給患者及其家庭帶來了沉重的身心負(fù)擔(dān)。而GIVI-MPC干細(xì)胞療法的獲批,不僅標(biāo)志著干細(xì)胞療法在肌營養(yǎng)不良癥領(lǐng)域取得了重要突破,更為類似罕見病的治療探索出了新的方向。
成就與機(jī)遇:干細(xì)胞治療研究的“進(jìn)階之路”
據(jù)弗若斯特沙利文數(shù)據(jù)顯示,自2015年以來,全球細(xì)胞基因治療行業(yè)開始迅速發(fā)展,從2016年到2020年,市場規(guī)模從5040萬美元增長到20.8億美元,預(yù)計(jì)到2025年,全球細(xì)胞基因治療市場規(guī)模將達(dá)到近305.4億美元。
2024年干細(xì)胞治療領(lǐng)域在基礎(chǔ)研究、臨床應(yīng)用、政策支持和市場等方面都取得了突破性的進(jìn)展,為未來干細(xì)胞治療的發(fā)展奠定了堅(jiān)實(shí)的基礎(chǔ)。同時(shí),要實(shí)現(xiàn)干細(xì)胞治療的廣泛應(yīng)用和產(chǎn)業(yè)化,還需要克服諸多挑戰(zhàn),需要政府、科研機(jī)構(gòu)、企業(yè)和社會各界的共同努力。
正如FDA孤兒藥資格認(rèn)證的獲得以及臨床試驗(yàn)的加速推進(jìn),IPS HEART的干細(xì)胞療法有望成為全球罕見病患者的新曙光,為他們帶來前所未有的治療希望和生命質(zhì)量的提升。相信在不久的將來,干細(xì)胞治療將為人類健康事業(yè)帶來更多的驚喜和福祉。
掃一掃,關(guān)注我們